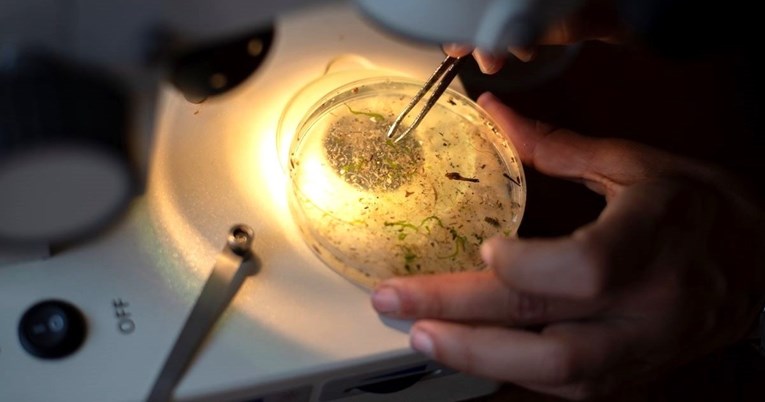
Smrt od kuge u Arizoni pokazuje da podmukla bolest nikad nije nestala

Smrt od kuge u Arizoni pokazuje da podmukla bolest nikad nije nestala
VIJEST o smrti od kuge u Arizoni, koju su potvrdile lokalne zdravstvene vlasti, odjeknula je kao snažan podsjetnik da opaka bolest koju često vežemo uz mračni srednji vijek nije nestala. Riječ je o prvom takvom smrtnom slučaju u toj američkoj saveznoj državi nakon gotovo dva desetljeća, što postavlja pitanje što je točno kuga i trebamo li se i danas brinuti zbog nje.
Tri lica opake bolesti
Iako riječ "kuga" u svakodnevnom govoru često koristimo za opisivanje bilo koje velike pošasti, u medicinskom smislu ona označava isključivo zaraznu bolest koju uzrokuje bakterija *Yersinia pestis*. Ovisno o tome kako se manifestira, razlikujemo tri glavna oblika: bubonski, septikemijski i plućni.
Bubonska kuga najčešći je oblik, a ime je dobila po bolnim i natečenim limfnim čvorovima, takozvanim bubonima. Uz njih, simptomi uključuju i visoku temperaturu, glavobolju, zimicu te opću slabost. Najčešće se prenosi ugrizom zaražene buhe koja živi na glodavcima poput štakora, prerijskih pasa ili svizaca. Do zaraze može doći i izravnim kontaktom sa zaraženom životinjom.
Ako se bubonska kuga ne liječi na vrijeme, bakterija može prodrijeti u krvotok i izazvati septikemijsku kugu. Ovaj oblik uzrokuje teško unutarnje krvarenje u organima i dobio je ime po septikemiji, odnosno teškoj infekciji krvi.
Plućna kuga, od koje je preminula osoba u Arizoni, najteži je i najopasniji oblik. Može se razviti kao komplikacija bubonske kuge, no za razliku od ostalih oblika, može se prenositi i kapljičnim putem s osobe na osobu, slično kao COVID-19. Simptomi su slični, ali uključuju i tešku upalu pluća. Bez hitnog liječenja, smrtnost kod bubonske kuge iznosi između 30 i 60 posto, dok kod plućnog oblika može doseći i 100 posto.
Pošast koja je oblikovala povijest
Kuga je ostavila dubok i smrtonosan trag u ljudskoj povijesti. Justinijanova kuga, koja je harala od 541. do 750. godine, usmrtila je desetke milijuna ljudi na području Sredozemlja i značajno utjecala na sudbinu Bizantskog Carstva. Stoljećima kasnije, "Crna smrt" je između 1346. i 1353. godine pokosila gotovo polovicu europskog stanovništva.
Treća velika pandemija, potaknuta širenjem trgovačkih puteva Britanskog Carstva, trajala je od sredine 19. stoljeća do otprilike 1960. godine. Vrhunac je dosegla početkom 20. stoljeća, odnijevši oko 12 milijuna života, uglavnom u Indiji. Vjeruje se da je iza svih ovih katastrofa stajala upravo bubonska kuga.
Kuga u 21. stoljeću: Rijetka, ali prisutna
Iako su pandemije stvar prošlosti, bakterija *Yersinia pestis* i dalje je prisutna u prirodi. U Sjedinjenim Državama, gdje se prvi put pojavila tijekom treće pandemije, kuga je endemska među populacijama prerijskih pasa i svizaca na zapadu zemlje. U prosjeku se zabilježi sedam slučajeva zaraze godišnje, a posljednja veća epidemija dogodila se prije stotinu godina. Smrtni ishodi iznimno su rijetki – u posljednjih 25 godina zabilježeno ih je tek 14.
Na globalnoj razini, tijekom posljednjeg desetljeća zabilježeno je nekoliko tisuća slučajeva. Zemlje s najvećim brojem zaraženih su Demokratska Republika Kongo, Madagaskar i Peru, no slučajevi se povremeno javljaju i u Indiji, središnjoj Aziji te SAD-u, uglavnom u ruralnim i poljoprivrednim područjima.
Liječenje postoji, no brzina je ključna
Dobra je vijest da se kuga danas uspješno liječi uobičajenim antibioticima, najčešće terapijom koja traje od 10 do 14 dana. Ipak, ključno je započeti s liječenjem što je prije moguće nakon pojave prvih simptoma.
Slučaj iz Arizone posebno je zabrinjavajući jer se radilo o plućnom obliku, jedinom koji se lako prenosi s čovjeka na čovjeka. Ipak, zasad nema dokaza o daljnjem širenju zaraze. Rizik od pojave kuge u Hrvatskoj, kao i u većini Europe, iznimno je malen jer bakterija nije prisutna u životinjskim populacijama.
Unatoč tome, stručnjaci upozoravaju da se kuga, kao i mnoge druge zarazne bolesti, ne smije podcjenjivati. Klimatske promjene mogle bi utjecati na širenje staništa životinja koje prenose bolest, zbog čega je nužan stalan oprez i nadzor javnozdravstvenih službi diljem svijeta. Smrt u Arizoni tragičan je podsjetnik da je kuga, iako drevna, i dalje stvarna prijetnja koja zahtijeva brzu i odlučnu reakciju.

bi Vas mogao zanimati
Izdvojeno
Pročitajte još
bi Vas mogao zanimati